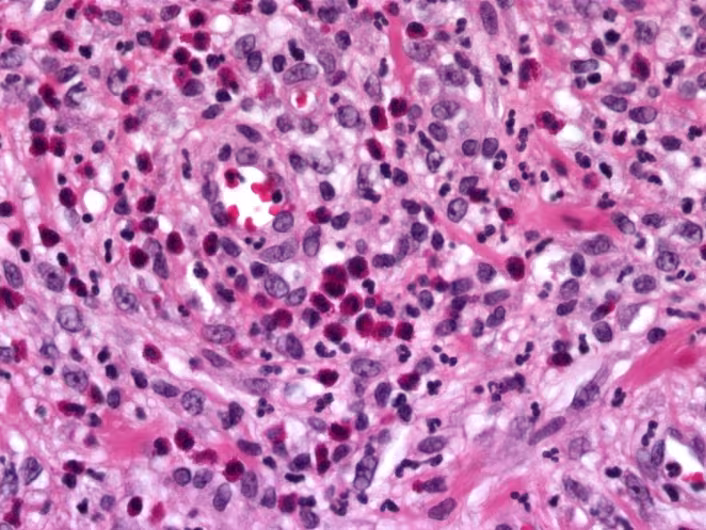

Painful Bump in Floor of Mouth
Case Challenge Number: 54
Diagnostic Information
History of Present Illness Carmen is a 62-year-old Hispanic female who reports with a chief complaint of, “I keep biting a bump in my mouth.” She has been aware of the lesion for the past 4 months and another dentist advised her it would “eventually” go away. Medical History
Adverse drug effects: none
Medications: metformin, glipizide, losartan, Lipitor, naproxen, Lexapro, amitriptyline, Allegra (prn)
Pertinent medical history: diabetes type 2; hypercholesterolemia; anxiety/depression; osteoarthritis; seasonal allergies
Pertinent family history: unknown, adopted
Social history: 50 pack year history cigarettes, stopped age 55; 1 six pack of beer / week; denies recreational drug exposure
Clinical Findings
BP: 156/72
Pulse: 91
Extra-Oral: TMJ normal, no muscle tenderness, no lymphadenopathy
Intraoral: A well-defined firm hyperkeratotic mass is noted originating from the FOM overlying the L sublingual fold (~ 1 cm x 1.5 cm) adjacent to #20. The mass has a distinct indentation that corresponds well with the lingual aspect #20 (Figures 1 and 2). An excisional biopsy is performed and the tissue submitted for histopathologic examination.
Figure 1. Anterior view of occlusion.
Figure 2. Ulcerated mass arising from the lower left aspect of the floor of the mouth.
Histopathologic Findings Sections show an ulcerated inflamed mucosal soft tissue fragment exhibiting a fibrinopurulent surface exudate with underlying acute and chronically inflamed edematous congested granulation tissue and deeper zone of vascular fibroplasia extending into atrophic skeletal muscle (Figure 3). There are numerous interspersed small-caliber to ectatic thin-walled vascular channels lined by plump reactive endothelial cells. The inflammatory infiltrate consists of neutrophils, eosinophils, lymphocytes, plasma cells and histiocytes (Figure 4). The specimen is partially surfaced by reactive stratified squamous epithelium exhibiting hyperplasia with elongated rete ridges, acanthosis, spongiosis, exocytosis, intracellular edema and hyperparakeratosis. There are proliferative epithelial changes with increased basal cellularity, slightly disordered maturation, inflammatory atypia, dyskeratosis and mitotic activity.
Figure 3. Low power image of specimen showing an ulcerated mucosal soft tissue fragment with fibrinous exudate and underlying inflamed granulation tissue. The adjacent epithelium displays hyperplasia and thin hyperkeratosis.
Figure 4. High power image of specimen demonstrating inflamed granulation tissue with acute and chronic inflammatory infiltrate containing numerous eosinophils.